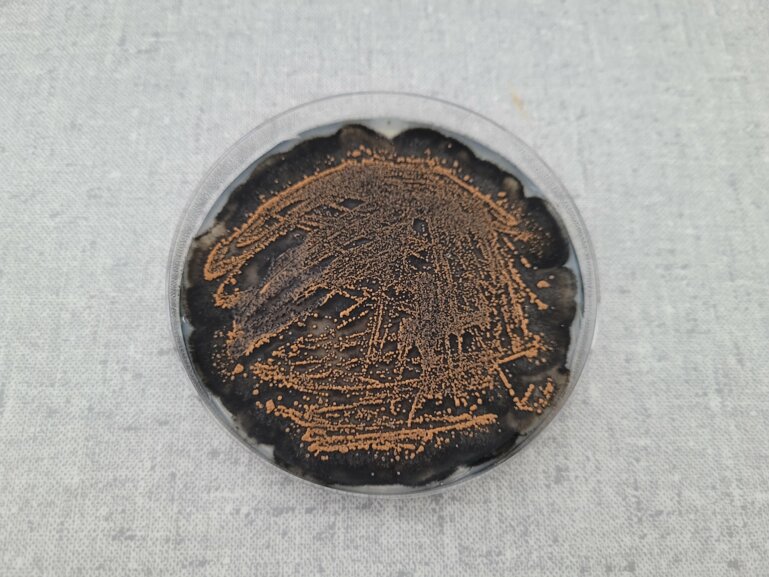
alt_text

En bref
– En sélection des plantes fourragères, on mise sur le rendement, la résilience et la tolérance par rapport au stress hydrique.
– La diversité génétique des variétés de population donne des peuplements plus résistants et s’adaptant mieux.
– Il faut notamment améliorer la résistance à la sécheresse ; de nouvelles espèces deviennent aussi plus intéressantes.
Quels sont les principaux buts en sélection des plantes fourragères ?
Michelle Nay : Pour qu’une variété soit commercialisée, elle doit passer les essais variétaux. Nous nous basons sur les critères fixés en la matière, soit le rendement, la résistance, la résilience, la persistance et la qualité. Pour que la variété soit admise, elle doit en outre réussir les tests de distinction et d’uniformité. Mais une bonne variété en soi ne suffit pas. Il faut aussi pouvoir produire des semences à partir de celle-ci en quantité suffisante, sinon les coûts sont trop élevés.
Les objectifs ont-ils changé au cours des dernières années ?
Michelle Nay : Oui, le dérèglement climatique fait changer les priorités : le rendement et la qualité des fourrages restent cruciaux, tandis que la résilience grâce à la tolérance au stress hydrique gagne en importance. En revanche, la tolérance au froid et la résistance à la moisissure des neiges en perdent. Quant à la résistance à l’anthracnose, elle est devenue indispensable pour la culture du trèfle violet en Suisse.
La sélection de plantes comme les graminées ou le trèfle diverge-t-elle de celle d’autres cultures ?
Christoph Grieder : Les plantes fourragères ont le plus souvent besoin d’un partenaire pollinisateur, ne pouvant pas s’autoféconder comme le blé. Une variété est cultivée en tant que population, c’est-à-dire comme un groupe formé de plusieurs individus, étant génétiquement plus diversifiée.
Cette particularité présente-t-elle des avantages pour les agriculteurs et les agricultrices ?
Christoph Grieder : Oui, absolument. La diversité génétique rend les variétés plus résistantes et plus résilientes. Il y en aura quelques-unes qui seront sensibles, ce qui est une bonne chose, car sinon, la pression sur le pathogène augmentera pour qu’il contourne la résistance.
Quels sont les critères les plus difficiles à réaliser ?
Christoph Grieder : Il s’agit clairement du rendement, qui est influencé par de nombreux gènes et présente une forte interaction avec l’environnement. Mais nous pouvons influer indirectement sur ce paramètre en améliorant la persistance des plantes. La résistance aux maladies joue également un rôle. D’une manière générale, tous les critères complexes à caractériser sont plus difficiles à réaliser, une situation qui s’explique aussi par le fait que nous pouvons tester moins de plantes. Cela concerne par exemple la digestibilité du fourrage.
Quel est l’âge des variétés cultivées ?
Christoph Grieder : En raison de leur diversité génétique et des progrès plus lents de la sélection, les variétés de plantes fourragères ont une durée de vie beaucoup plus longue que d’autres plantes cultivées. La variété de ray-grass Arvicola a été recommandée de 1996 à 2022, alors qu’elle date de 1989. Les variétés de plantes fourragères sont sur le marché depuis dix à vingt ans.
Combien de temps faut-il pour que les exploitations aient une nouvelle variété de trèfle ou de graminées ?
Michelle Nay : Depuis le premier croisement – c’est-à-dire la nouvelle combinaison de deux populations existantes – il faut au moins seize ans. Notre partenaire DSP se charge ensuite de la production et de la commercialisation de nos variétés.
Le critère souhaité (p. ex. résistance) est-il encore d’actualité quand les exploitations reçoivent la variété ?
Christoph Grieder : Un agent pathogène peut évoluer au fil des ans, mais c’est aussi le cas des plantes. Une sélection automatique a lieu dans l’environnement naturel à travers toutes les étapes de la sélection. Les plantes sensibles aux agents pathogènes qui apparaissent à ce moment-là meurent ou sont éliminées par nos soins.
Combien de temps dure la résistance ?
Michelle Nay : Les résistances se maintiennent plus longtemps chez les variétés de population, car elles exercent une pression d’adaptation moindre sur le pathogène. Les prairies naturelles environnantes renforcent cet effet. Comme nous ne sélectionnons que sur la base du phénotype (c.-à-d. de l’aspect extérieur de la plante), nous ne savons cependant pas quelles résistances sont présentes et quand elles disparaîtront.
Quelles sont les difficultés actuelles des exploitations ?
Michelle Nay : La sécheresse estivale peut devenir plus fréquente. Il en va de même des conditions humides (c’était le cas cette année). Il importe donc pour nous d’améliorer la résilience des plantes. En ce qui concerne les animaux, la difficulté consiste à produire un bon fourrage de base afin de ne pas dépendre des aliments concentrés.
Comment réagissez-vous à ces enjeux en tant que sélectionneurs ?
Christoph Grieder : S’agissant des plantes fourragères, nous avons une grande flexibilité au niveau des espèces. Nous essayons d’accroître la tolérance par rapport à la sécheresse des espèces existantes (p. ex. raygrass). Aussi nous testons les variétés dans une tente de stress hydrique. Nous repoussons le plus possible les limites des espèces pour proposer ce qui est requis. Mais nous misons aussi sur les espèces qui supportent mieux la sécheresse (p. ex. luzerne ou fétuque élevée). Celles-ci ont malheureusement des inconvénients que nous essayons de pallier. Pour la luzerne, nous tentons d’améliorer la souplesse d’utilisation. Si elles ne sont pas coupées pendant lontemps, les tiges doivent tout de même être bien digestibles et ne pas être trop dures pour éviter qu’elles ne percent les balles d’ensilage. Pour la fétuque élevée, nous travaillons à une meilleure digestibilité.
Michelle Nay : A l’origine, cette plante a des fibres très dures. Il peut même arriver que l’on se coupe en y passant la main. Et le rendement des semences n’est pas satisfaisant.
Des progrès ont-ils déjà été réalisés ?
Christoph Grieder : Deux générations sous la tente de stress hydrique ont montré de légères améliorations chez le ray-grass. Mais il faut encore évaluer comment ces résultats se traduisent dans les champs. Un semis plus profond pourrait être utile dans la phase d’établissement. La tolérance face au stress hydrique est complexe. Les plantes recourent à des stratégies extrêmes : la luzerne fait des racines plus profondes pour continuer à pousser facilement. D’autres espèces réduisent leur croissance pour bien surmonter le stress hydrique, compensant cette dernière par la suite.
La situation climatique se reflète-t-elle aussi dans la demande pour les espèces ? Quelles sont les tendances ?
Michelle Nay : La demande pour la fétuque élevée est clairement en hausse. La fétuque des prés tétraploïde hautement digestible est recherchée à l’étranger. S’agissant du trèfle violet pour la pâture, l’engouement s’est à nouveau calmé. Quant aux espèces herbacées comme la chicorée ou le plantain lancéolé – que nous ne sélectionnons pas (encore), elles sont de plus en plus demandées dans les pays européens. Selon des études, le plantain lancéolé ayant un effet diurétique chez l’animal, il réduit la teneur en azote dans l’urine et les pertes.
Y a-t-il des espèces de plantes fourragères peu usitées prometteuses ?
Michelle Nay : Avec sa teneur élevée en tanins condensés, l’esparcette reste une bonne option. Mais son rendement de semences étant faible et ses exigences spécifiques en matière d’emplacement étant élevées, cette plante n’est pas encore très présente sur le marché. Les espèces herbacées, en particulier le plantain lancéolé, ont un grand potentiel, mais nécessitent encore un travail de sélection pour être adaptées aux conditions de culture fourragère suisse.
Sélectionnez-vous également des variétés pour l’agriculture biologique ?
Christoph Grieder : Nous sommes les seuls en Europe à sélectionner aussi des plantes fourragères pour le secteur bio. Celles-ci sont sélectionnées spécifiquement dans des conditions de production bio et entrent alors dans la catégorie 2 de Bio Suisse. Mais en principe, les exigences posées à ces variétés sont très similaires à celles de la production fourragère conventionnelle.
Sélectionnez-vous l’aptitude pour les cultures mélangées ?
Christoph Grieder : La sélection de l’aptitude au mélange est éminemment complexe, car il faut prendre en compte de très nombreux paramètres. Mais nous savons que la performance propre de la plante est fortement corrélée à la performance dans le mélange. De plus, nous travaillons avec du pâturin des prés en tant que sous-semis dans le jardin de sélection, ce qui reproduit quelque peu la situation du mélange.
Quelles innovations y aura-t-il dans la sélection des plantes fourragères au cours de la prochaine décennie ?
Michelle Nay : La mise en œuvre de la sélection génomique va certainement prendre de l’ampleur dans le domaine des plantes fourragères. Nous espérons ainsi soutenir la sélection et améliorer plus rapidement un plus grand nombre de critères. Nous lançons actuellement un projet de recherche à ce sujet.
Notre conseil
Conseils de culture des sélectionneurs
– Ne pas économiser sur les semences, surtout pour les cultures de longue durée. Utiliser des mélanges certifiés par l’ADCF ou des mélanges du commerce correspondants : contenant exclusivement des variétés recommandées, ces mélanges permettent de bénéficier du travail de sélection et offrent bon niveau de résistance.
– Prévenir les maladies. La sclérotiniose attaquant les plantes en automne et passant ensuite l’hiver, il est judicieux de ne pas laisser la culture être trop luxuriante en hiver et de faire une pause dans la culture en cas d’infestation importante.